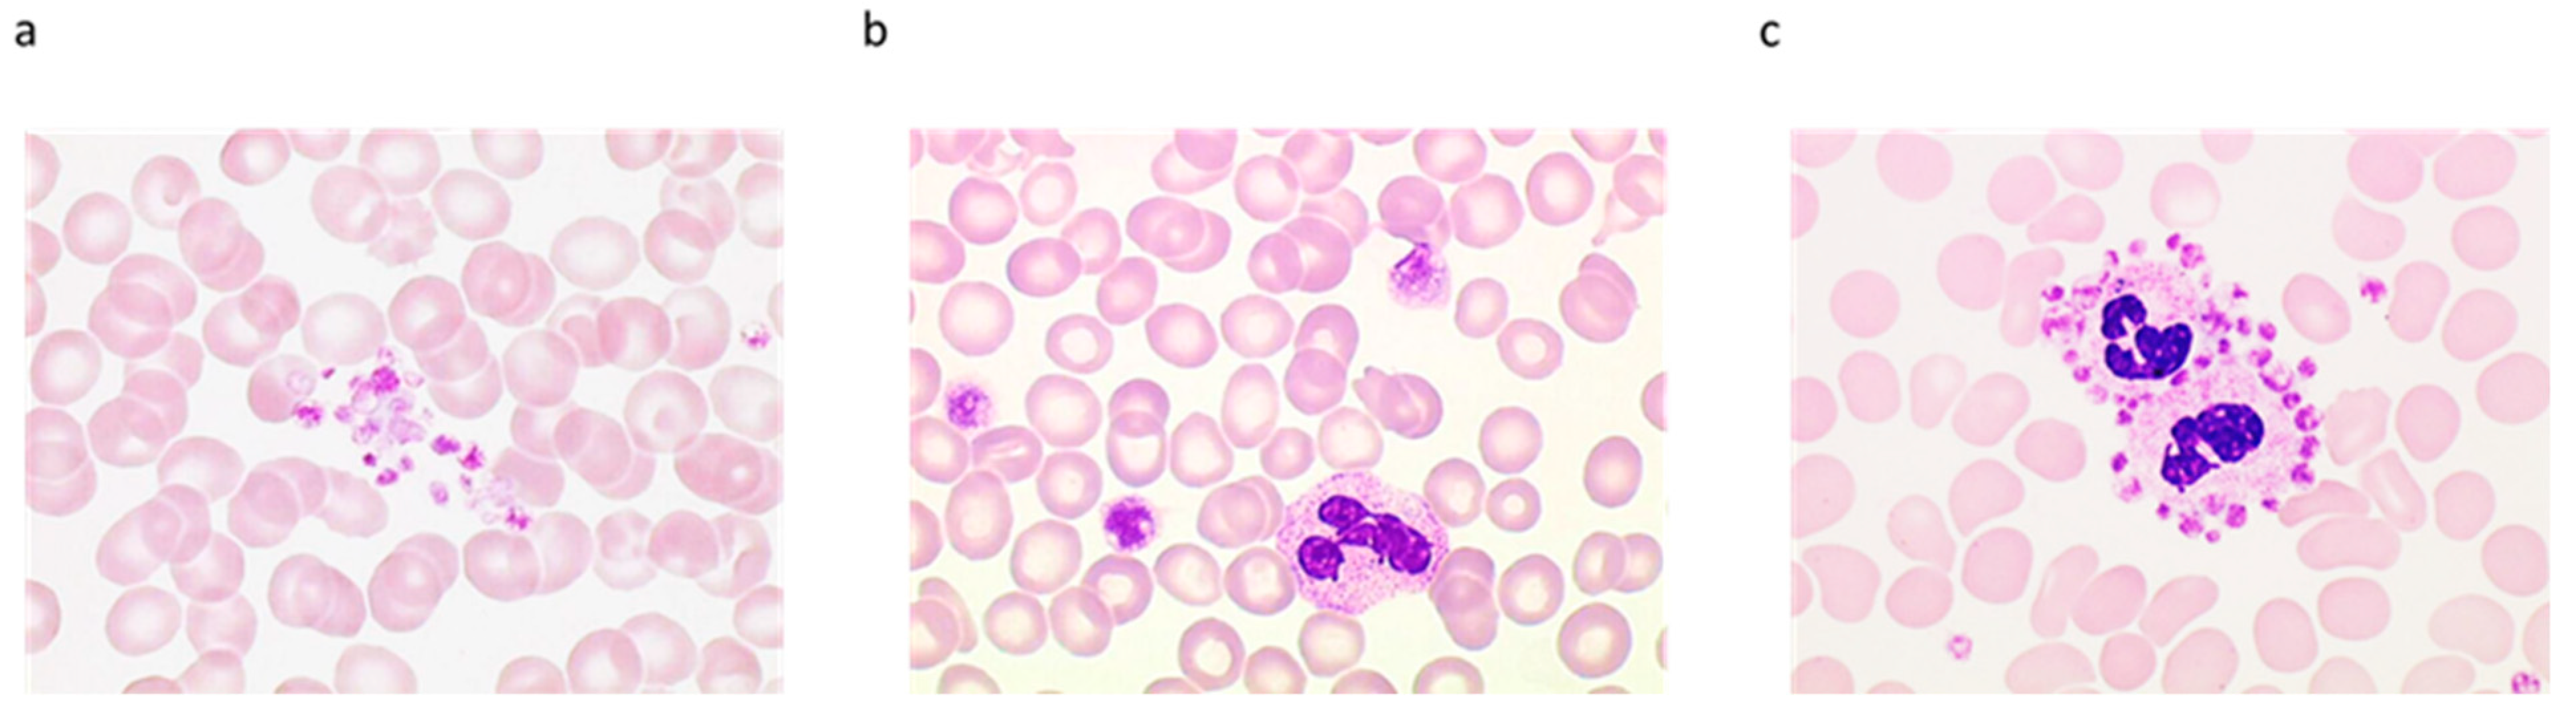
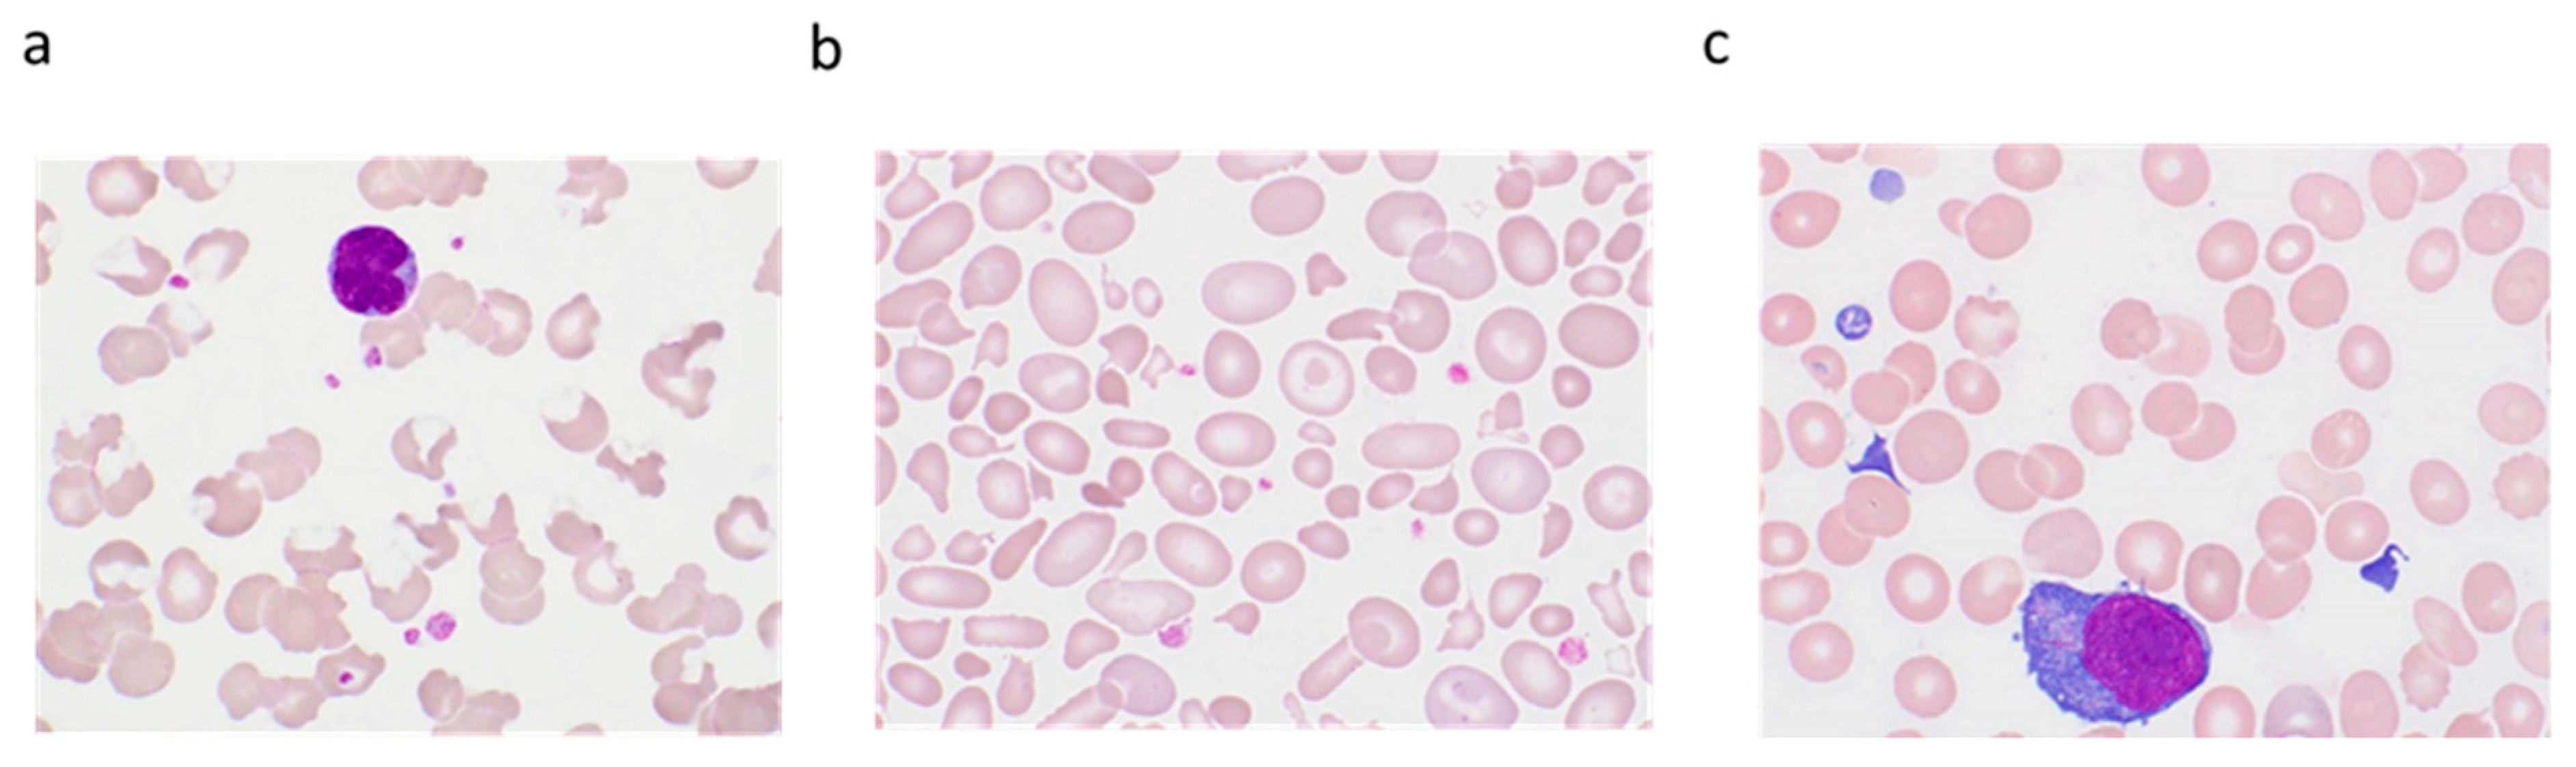

Platelet Counting: Ugly Traps and Good Advice. Proposals from the French-Speaking Cellular Hematology Group (GFHC)
Abstract
1. Introduction
2. Platelet Count
2.1. Different Counting Techniques
2.1.1. Microscopic Methods
2.1.2. Immunoplatelet Counting
2.1.3. Impedance Platelet Counting
2.1.4. Optical Platelet Counting
2.1.5. Fluorescence Platelet Counting
2.2. Platelet Count Normal Reference Values and Thresholds for Checking and Verification
2.2.1. Platelet Count Normal Reference Values
2.2.2. Which Quantitative Thresholds should be Considered to Trigger Additional Actions before Reporting the Result?
2.2.3. Pre-Analytical Errors
3. Technical and Biological Validations of Platelet Count: GFHC Guidelines
3.1. Technical Validation: How to Check a Platelet Count?
3.2. Biological Validation
3.3. Facing Thrombocytopenia or a Significant Decrease in Platelet Count
3.3.1. Technical Validation: Search for Analytical Pitfalls that Cause Artefactual Reduction of the Platelet Count
Platelet Clumps
Large Platelets. Definition, Circumstances, and How They Disturb the Platelet Count
Platelet Satellitism
3.3.2. Facing Real Thrombocytopenia: Which Investigations Are Necessary? How Can We Guide Clinical Management?
3.4. Facing Thrombocytosis or a Significant Increase in the Platelet Count Compared with a Previous Result
3.4.1. Technical Validation Step: Research and Identification of Interferences that could Result in Overestimation of Platelets
Cryoglobulins
Extreme Microcytosis and Red Cell Fragments
Cytoplasmic Debris from Nucleated Cells
Lipids
Microorganisms
How to Report the Result?
3.4.2. Facing Real Thrombocytosis: Which Investigations are Necessary? How can We Guide Clinical Management?
4. Unanswered Questions and Concluding Remarks
Author Contributions
Funding
Acknowledgments
Conflicts of Interest
References
- Brecher, G.; Schneiderman, M.; Cronkite, E.P. The reproducibility and constancy of the platelet count. Am. J. Clin. Pathol. 1953, 23, 15–26. [Google Scholar] [CrossRef] [PubMed]
- Noris, P.; Klersy, C.; Zecca, M.; Arcaini, L.; Pecci, A.; Melazzini, F.; Terulla, V.; Bozzi, V.; Ambaglio, C.; Passamonti, F.; et al. Platelet size distinguishes between inherited macrothrombocytopenias and immune thrombocytopenia. J. Thromb. Haemost. 2009, 7, 2131–2136. [Google Scholar] [CrossRef] [PubMed]
- Salignac, S.; Latger-Cannard, V.; Schlegel, N.; Lecompte, T.P. Platelet counting. Methods Mol. Biol. (Clifton, N. J.) 2013, 992, 193–205. [Google Scholar] [CrossRef]
- Fonio, A. Ueber ein neues verfahren der blutplattchenzahlung. Deustche Zeitschrieft Chir. 1912, 117, 176–194. [Google Scholar] [CrossRef]
- Anchinmane, V.; Sankhe, S. Utility of peripheral blood smear in platelet count estimation. Int. J. Res. Med. Sci. 2019, 7, 434–437. [Google Scholar] [CrossRef]
- Malok, M.; Titchener, E.H.; Bridgers, C.; Lee, B.Y.; Bamberg, R. Comparison of two platelet count estimation methodologies for peripheral blood smears. Clin. Lab. Sci. J. Am. Soc. Med. Technol. 2007, 20, 154–160. [Google Scholar]
- Sutor, A.H.; Grohmann, A.; Kaufmehl, K.; Wündisch, T. Problems with platelet counting in thrombocytopenia. A rapid manual method to measure low platelet counts. Semin. Thromb. Hemost. 2001, 27, 237–243. [Google Scholar] [CrossRef]
- Gao, Y.; Mansoor, A.; Wood, B.; Nelson, H.; Higa, D.; Naugler, C. Platelet count estimation using the CellaVision DM96 system. J. Pathol. Inf. 2013, 4, 16. [Google Scholar] [CrossRef]
- Harrison, P.; Ault, K.A.; Chapman, S.; Charie, L.; Davis, B.; Fujimoto, K.; Houwen, B.; Kunicka, J.; Lacombe, F.; Machin, S.; et al. An interlaboratory study of a candidate reference method for platelet counting. Am. J. Clin. Pathol. 2001, 115, 448–459. [Google Scholar] [CrossRef]
- Harrison, P.; Horton, A.; Grant, D.; Briggs, C.; MacHin, S. Immunoplatelet counting: A proposed new reference procedure. Br. J. Haematol. 2000, 108, 228–235. [Google Scholar] [CrossRef]
- International Council for Standardization in Haematology Expert Panel on Cytometry; International Society of Laboratory Hematology Task Force on Platelet Counting. Platelet counting by the RBC/platelet ratio method. A reference method. Am. J. Clin. Pathol. 2001, 115, 460–464. [Google Scholar] [CrossRef]
- Norris, S.; Pantelidou, D.; Smith, D.; Murphy, M.F. Immunoplatelet counting: Potential for reducing the use of platelet transfusions through more accurate platelet counting. Br. J. Haematol. 2003, 121, 605–613. [Google Scholar] [CrossRef] [PubMed]
- Patterson, K. Platelet parameters generated by automated blood counters. CME Bull. Hematol. 1997, 1, 13–16. [Google Scholar]
- Mie, G. Beiträge zur Optik trüber Medien, speziell kolloidaler Metallösungen. Ann. Phys. 1908, 25, 377–445. [Google Scholar] [CrossRef]
- Harris, N.; Kunicka, J.; Kratz, A. The ADVIA 2120 hematology system: Flow cytometry-based analysis of blood and body fluids in the routine hematology laboratory. Lab. Hematol. Off. Publ. Int. Soc. Lab. Hematol. 2005, 11, 47–61. [Google Scholar] [CrossRef] [PubMed]
- Hummel, K.; Sachse, M.; Hoffmann, J.; van Dun, L. Comparative evaluation of platelet counts in two hematology analyzers and potential effects on prophylactic platelet transfusion decisions. Transfusion 2018, 58, 2301–2308. [Google Scholar] [CrossRef]
- Briggs, C.; Longair, I.; Kumar, P.; Singh, D.; Machin, S.J. Performance evaluation of the Sysmex haematology XN modular system. J. Clin. Pathol. 2012, 65, 1024–1030. [Google Scholar] [CrossRef]
- Schoorl, M.; Schoorl, M.; Oomes, J.; van Pelt, J. New fluorescent method (PLT-F) on Sysmex XN2000 hematology analyzer achieved higher accuracy in low platelet counting. Am. J. Clin. Pathol. 2013, 140, 495–499. [Google Scholar] [CrossRef]
- D’Souza, C.; Briggs, C.; Machin, S.J. Platelets: The few, the young, and the active. Clin. Lab. Med. 2015, 35, 123–131. [Google Scholar] [CrossRef]
- Hoffmann, J.J.M.L. Reticulated platelets: Analytical aspects and clinical utility. Clin. Chem. Lab. Med. 2014, 52, 1107–1117. [Google Scholar] [CrossRef]
- Imperiali, C.E.; Arbiol-Roca, A.; Sanchez-Navarro, L.; Dastis-Arias, M.; Lopez-Delgado, J.C.; Cortes-Bosch, A.; Sancho-Cerro, A.; Dot-Bach, D. Reference interval for immature platelet fraction on Sysmex XN haematology analyser in adult population. Biochem. Med. (Zagreb) 2018, 28, 010708. [Google Scholar] [CrossRef] [PubMed]
- Ali, U.; Knight, G.; Gibbs, R.; Tsitsikas, D.A. Reference intervals for absolute and percentage immature platelet fraction using the Sysmex XN-10 automated haematology analyser in a UK population. Scand. J. Clin. Lab. Investig. 2017, 77, 658–664. [Google Scholar] [CrossRef] [PubMed]
- Have, L.W.J.; Hasle, H.; Vestergaard, E.M.; Kjaersgaard, M. Absolute immature platelet count may predict imminent platelet recovery in thrombocytopenic children following chemotherapy. Pediatr. Blood Cancer 2013, 60, 1198–1203. [Google Scholar] [CrossRef] [PubMed]
- MacQueen, B.C.; Christensen, R.D.; Henry, E.; Romrell, A.M.; Pysher, T.J.; Bennett, S.T.; Sola-Visner, M.C. The immature platelet fraction: Creating neonatal reference intervals and using these to categorize neonatal thrombocytopenias. J. Perinatol. Off. J. Calif. Perinat. Assoc. 2017, 37, 834–838. [Google Scholar] [CrossRef]
- Van De Wyngaert, Z.; Fournier, E.; Bera, E.; Carrette, M.; Soenen, V.; Gauthier, J.; Preudhomme, C.; Boyer, T. Immature platelet fraction (IPF): A reliable tool to predict peripheral thrombocytopenia. Curr. Res. Transl. Med. 2019. [Google Scholar] [CrossRef]
- Li, J.; Li, Y.; Ouyang, J.; Zhang, F.; Liang, C.; Ye, Z.; Chen, S.; Cheng, J. Immature platelet fraction related parameters in the differential diagnosis of thrombocytopenia. Platelets 2019. [Google Scholar] [CrossRef]
- Ferreira, F.L.B.; Colella, M.P.; Medina, S.S.; Costa-Lima, C.; Fiusa, M.M.L.; Costa, L.N.G.; Orsi, F.A.; Annichino-Bizzacchi, J.M.; Fertrin, K.Y.; Gilberti, M.F.P.; et al. Evaluation of the immature platelet fraction contribute to the differential diagnosis of hereditary, immune and other acquired thrombocytopenias. Sci. Rep. 2017, 7, 3355. [Google Scholar] [CrossRef]
- Miyazaki, K.; Koike, Y.; Kunishima, S.; Ishii, R.; Danbara, M.; Horie, R.; Yatomi, Y.; Higashihara, M. Immature platelet fraction measurement is influenced by platelet size and is a useful parameter for discrimination of macrothrombocytopenia. Hematology 2015, 20, 587–592. [Google Scholar] [CrossRef]
- Wada, A.; Takagi, Y.; Kono, M.; Morikawa, T. Accuracy of a new Platelet Count System (PLT-F) depends on the staining property of its reagents. PLoS ONE 2015, 10, e0141311. [Google Scholar] [CrossRef]
- Greene, L.A.; Chen, S.; Seery, C.; Imahiyerobo, A.M.; Bussel, J.B. Beyond the platelet count: Immature platelet fraction and thromboelastometry correlate with bleeding in patients with immune thrombocytopenia. Br. J. Haematol. 2014, 166, 592–600. [Google Scholar] [CrossRef]
- Barsam, S.J.; Psaila, B.; Forestier, M.; Page, L.K.; Sloane, P.A.; Geyer, J.T.; Villarica, G.O.; Ruisi, M.M.; Gernsheimer, T.B.; Beer, J.H.; et al. Platelet production and platelet destruction: Assessing mechanisms of treatment effect in immune thrombocytopenia. Blood 2011, 117, 5723–5732. [Google Scholar] [CrossRef] [PubMed]
- Perl, L.; Matatov, Y.; Koronowski, R.; Lev, E.I.; Solodky, A. Prognostic significance of reticulated platelet levels in diabetic patients with stable coronary artery disease. Platelets 2019. [Google Scholar] [CrossRef] [PubMed]
- Huang, H.L.; Chen, C.H.; Kung, C.T.; Li, Y.C.; Sung, P.H.; You, H.L.; Lin, Y.H.; Huang, W.T. Clinical utility of mean platelet volume and immature platelet fraction in acute coronary syndrome. Biomed. J. 2019, 42, 107–115. [Google Scholar] [CrossRef] [PubMed]
- Haute Autorité de Santé” (HAS). Lecture Critique de L’hémogramme: Valeurs Seuils à Reconnaître Comme Probablement Pathologiques et Principales Variations non Pathologiques; HAS: La Plaine Saint-Denis, French, 1997. [Google Scholar]
- Kratz, A.; Ferraro, M.; Sluss, P.M.; Lewandrowski, K.B. Case records of the Massachusetts General Hospital. Weekly clinicopathological exercises. Laboratory reference values. N. Engl. J. Med. 2004, 351, 1548–1563. [Google Scholar] [CrossRef] [PubMed]
- Wakeman, L.; Al-Ismail, S.; Benton, A.; Beddall, A.; Gibbs, A.; Hartnell, S.; Morris, K.; Munro, R. Robust, routine haematology reference ranges for healthy adults. Int. J. Lab. Hematol. 2007, 29, 279–283. [Google Scholar] [CrossRef] [PubMed]
- Troussard, X.; Vol, S.; Cornet, E.; Bardet, V.; Couaillac, J.-P.; Fossat, C.; Luce, J.-C.; Maldonado, E.; Siguret, V.; Tichet, J.; et al. Full blood count normal reference values for adults in France. J. Clin. Pathol. 2014, 67, 341–344. [Google Scholar] [CrossRef]
- Houwen, B. Random errors in haematology tests: A process control approach. Clin. Lab. Haematol. 1990, 12 (Suppl. 1), 157–168, discussion 169–170. [Google Scholar]
- Barnes, P.W.; McFadden, S.L.; Machin, S.J.; Simson, E.; hematology, i.c.g.f. The international consensus group for hematology review: Suggested criteria for action following automated CBC and WBC differential analysis. Lab. Hematol. Off. Publ. Int. Soc. Lab. Hematol. 2005, 11, 83–90. [Google Scholar] [CrossRef]
- Geneviève, F.; Galoisy, A.C.; Mercier-Bataille, D.; Wagner-Ballon, O.; Trimoreau, F.; Fenneteau, O.; Schillinger, F.; Leymarie, V.; Girard, S.; Settegrana, C.; et al. Revue microscopique du frottis sanguin: Propositions du Groupe Francophone d’Hématologie Cellulaire (GFHC). Feuillets Biol. 2014, 317, 7–14. [Google Scholar]
- England, J.M.; Rowan, R.M.; van Assendelft, O.W.; Bull, B.S.; Coulter, W.; Fujimoto, K.; Groner, W.; Richardson-Jones, A.; Klee, G.; Koepke , J.A. Recommendations of the International Council for Standardization in Haematology for Ethylenediaminetetraacetic Acid Anticoagulation of Blood for Blood Cell Counting and Sizing: International council for standardization in haematology: Expert panel on cytometry. Am. J. Clin. Pathol. 1993, 100, 371–372. [Google Scholar] [CrossRef]
- Zandecki, M.; Genevieve, F.; Gerard, J.; Godon, A. Spurious counts and spurious results on haematology analysers: A review. Part I: Platelets. Int. J. Lab. Hematol. 2007, 29, 4–20. [Google Scholar] [CrossRef] [PubMed]
- Zerah, S.; McMurray, J.; Horvath, A.R. Our profession now has a European name: Specialist in laboratory medicine. Biochem. Med. (Zagreb) 2012, 22, 272–273. [Google Scholar] [CrossRef]
- Chae, H.; Kim, M.; Lim, J.; Oh, E.J.; Kim, Y.; Han, K. Novel method to dissociate platelet clumps in EDTA-dependent pseudothrombocytopenia based on the pathophysiological mechanism. Clin. Chem. Lab. Med. 2012, 50, 1387–1391. [Google Scholar] [CrossRef] [PubMed]
- Dabadie, M.; Valli, N.; Jacobin, M.J.; Laroche-Traineau, J.; Barat, J.L.; Ducassou, D.; Nurden, A.T.; Clofent-Sanchez, G. Characterisation, cloning and sequencing of a conformation-dependent monoclonal antibody to the alphaIIbbeta3 integrin: Interest for use in thrombus detection. Platelets 2001, 12, 395–405. [Google Scholar] [CrossRef] [PubMed]
- Hultin, M.B.; Sussman, II. Postoperative thrombocytopenia in type IIB von Willebrand disease. Am. J. Hematol. 1990, 33, 64–68. [Google Scholar] [CrossRef]
- Kabutomori, O.; Iwatani, Y. “Correct” platelet count in EDTA-dependent pseudothrombocytopenia. Eur. J. Haematol. 1995, 55, 67–68. [Google Scholar] [CrossRef]
- Sassi, M.; Dibej, W.; Abdi, B.; Abderrazak, F.; Hassine, M.; Babba, H. Diagnostic performance of graphical anomalies in the detection of large platelets and platelet clumps. Pathol. Biol. (Paris) 2015, 63, 248–251. [Google Scholar] [CrossRef]
- Lippi, G.; Guidi, G.; Nicoli, M. Platelet count in EDTA-dependent pseudothrombocytopenia. Eur. J. Haematol. 1996, 56, 112–113. [Google Scholar] [CrossRef]
- Bizzaro, N. EDTA-dependent pseudothrombocytopenia: A clinical and epidemiological study of 112 cases, with 10-year follow-up. Am. J. Hematol. 1995, 50, 103–109. [Google Scholar] [CrossRef]
- Vedy, S.; Boom, B.; Perez, P.; Schillinger, S.; Ragot, C.; Bakkouch, S.; Puyhardy, J.M. Automatic platelets numbering with citrate as anticoagulant: Is the result valid? Ann. Biol. Clin. (Paris) 2011, 69, 453–458. [Google Scholar] [CrossRef]
- Lippi, U.; Schinella, M.; Modena, N.; Nicoli, M.; Lippi, G. Advantages of a new anticoagulant in routine hematology on the Coulter Counter S-Plus STKR analyzer. Am. J. Clin. Pathol. 1990, 93, 760–764. [Google Scholar] [CrossRef] [PubMed]
- Lippi, U.; Schinella, M.; Nicoli, M.; Modena, N.; Lippi, G. EDTA-induced platelet aggregation can be avoided by a new anticoagulant also suitable for automated complete blood count. Haematologica 1990, 75, 38–41. [Google Scholar] [PubMed]
- Lin, J.; Luo, Y.; Yao, S.; Yan, M.; Li, J.; Ouyang, W.; Kuang, M. Discovery and correction of spurious low platelet counts due to EDTA-dependent pseudothrombocytopenia. J. Clin. Lab. Anal. 2015, 29, 419–426. [Google Scholar] [CrossRef] [PubMed]
- Sakurai, S.; Shiojima, I.; Tanigawa, T.; Nakahara, K. Aminoglycosides prevent and dissociate the aggregation of platelets in patients with EDTA-dependent pseudothrombocytopenia. Br. J. Haematol. 1997, 99, 817–823. [Google Scholar] [CrossRef] [PubMed]
- Zhou, X.; Wu, X.; Deng, W.; Li, J.; Luo, W. Amikacin can be added to blood to reduce the fall in platelet count. Am. J. Clin. Pathol. 2011, 136, 646–652. [Google Scholar] [CrossRef]
- Barradas, M.A.; Mikhailidis, D.P.; Epemolu, O.; Jeremy, J.Y.; Fonseca, V.; Dandona, P. Comparison of the platelet pro-aggregatory effect of conventional unfractionated heparins and a low molecular weight heparin fraction (CY 222). Br. J. Haematol. 1987, 67, 451–457. [Google Scholar] [CrossRef]
- Dumont, P.; Goussot, V.; David, A.; Lizard, S.; Riedinger, J.M. Identification and validation of a factor of commutability between platelet counts performed on EDTA and citrate. Ann. Biol. Clin. (Paris) 2017, 75, 61–66. [Google Scholar] [CrossRef]
- Granat, F.; Geffré, A.; Braun, J.-P.; Trumel, C. Comparison of platelet clumping and complete blood count results with Sysmex XT-2000iV in feline blood sampled on EDTA or EDTA plus CTAD (citrate, theophylline, adenosine and dipyridamole). J. Feline Med. Surg. 2011, 13, 953–958. [Google Scholar] [CrossRef]
- Granat, F.A.; Geffré, A.; Lucarelli, L.A.; Braun, J.-P.D.; Trumel, C.; Bourgès-Abella, N.H. Evaluation of CTAD (citrate-theophylline-adenosine-dipyridamole) as a universal anticoagulant in dogs. J. Vet. Diagn. Investig. Off. Publ. Am. Assoc. Vet. Lab. Diagn. Inc. 2017, 29, 676–682. [Google Scholar] [CrossRef]
- Yokota, M.; Tatsumi, N.; Tsuda, I.; Nishioka, T.; Takubo, T. CTAD as a universal anticoagulant. J. Autom. Methods Manag. Chem. 2003, 25, 17–20. [Google Scholar] [CrossRef]
- Francois, D.; Masure, A.; Atallah, N.; Touil, L.; Vasse, M. Underestimation of platelet count on magnesium salt-anticoagulated samples. Clin. Chem. Lab. Med. 2014, 52, e95–e97. [Google Scholar] [CrossRef] [PubMed]
- Schuff-Werner, P.; Steiner, M.; Fenger, S.; Gross, H.J.; Bierlich, A.; Dreissiger, K.; Mannuss, S.; Siegert, G.; Bachem, M.; Kohlschein, P. Effective estimation of correct platelet counts in pseudothrombocytopenia using an alternative anticoagulant based on magnesium salt. Br. J. Haematol. 2013, 162, 684–692. [Google Scholar] [CrossRef] [PubMed]
- Lippi, G.; Plebani, M. EDTA-dependent pseudothrombocytopenia: Further insights and recommendations for prevention of a clinically threatening artifact. Clin. Chem. Lab. Med. 2012, 50, 1281–1285. [Google Scholar] [CrossRef] [PubMed]
- Noris, P.; Biino, G.; Pecci, A.; Civaschi, E.; Savoia, A.; Seri, M.; Melazzini, F.; Loffredo, G.; Russo, G.; Bozzi, V.; et al. Platelet diameters in inherited thrombocytopenias: Analysis of 376 patients with all known disorders. Blood 2014, 124, e4–e10. [Google Scholar] [CrossRef] [PubMed]
- Palmer, L.; Briggs, C.; McFadden, S.; Zini, G.; Burthem, J.; Rozenberg, G.; Proytcheva, M.; Machin, S.J. ICSH recommendations for the standardization of nomenclature and grading of peripheral blood cell morphological features. Int. J. Lab. Hematol. 2015, 37, 287–303. [Google Scholar] [CrossRef]
- Latger-Cannard, V.; Hoarau, M.; Salignac, S.; Baumgart, D.; Nurden, P.; Lecompte, T. Mean platelet volume: Comparison of three analysers towards standardization of platelet morphological phenotype. Int. J. Lab. Hematol. 2012, 34, 300–310. [Google Scholar] [CrossRef]
- Baccini, V.; Alessi, M.C. Diagnosis of inherited thrombocytopenia. Rev. Med. Interne 2016, 37, 117–126. [Google Scholar] [CrossRef]
- Harrison, P.; Goodall, A.H. Studies on Mean Platelet Volume (MPV)—New editorial policy. Platelets 2016, 27, 605–606. [Google Scholar] [CrossRef]
- Demirin, H.; Ozhan, H.; Ucgun, T.; Celer, A.; Bulur, S.; Cil, H.; Gunes, C.; Yildirim, H.A. Normal range of mean platelet volume in healthy subjects: Insight from a large epidemiologic study. Thromb. Res. 2011, 128, 358–360. [Google Scholar] [CrossRef]
- Hoffmann, J.J.M.L. Reference range of mean platelet volume. Thromb. Res. 2012, 129, 534–535. [Google Scholar] [CrossRef]
- Lippi, G.; Meschi, T.; Borghi, L. Mean platelet volume increases with aging in a large population study. Thromb. Res. 2012, 129, e159–e160. [Google Scholar] [CrossRef] [PubMed]
- Bessman, D. Prediction of platelet production during chemotherapy of acute leukemia. Am. J. Hematol. 1982, 13, 219–227. [Google Scholar] [CrossRef] [PubMed]
- Karpatkin, S. Heterogeneity of human platelets. VI. Correlation of platelet function with platelet volume. Blood 1978, 51, 307–316. [Google Scholar] [CrossRef] [PubMed]
- Ittermann, T.; Feig, M.A.; Petersmann, A.; Radke, D.; Greinacher, A.; Völzke, H.; Thiele, T. Mean platelet volume is more important than age for defining reference intervals of platelet counts. PLoS ONE 2019, 14, e0213658. [Google Scholar] [CrossRef] [PubMed]
- Cesca, C.; Ben-Ezra, J.; Riley, R.S. Platelet satellitism as presenting finding in mantle cell lymphoma. A case report. Am. J. Clin. Pathol. 2001, 115, 567–570. [Google Scholar] [CrossRef] [PubMed]
- Latger-Cannard, V.; Debourgogne, A.; Montagne, K.; Plenat, F.; Lecompte, T. Platelet satellitism and lympho-agglutination as presenting finding in marginal zone B-cell lymphoma. Eur. J. Haematol. 2009, 83, 81–82. [Google Scholar] [CrossRef]
- Hammerstrom, J. Spurious platelet counts in acute leukaemia with DIC due to cell fragmentation. Clin. Lab. Haematol. 1992, 14, 239–243. [Google Scholar] [CrossRef]
- Li, S.; Salhany, K.E. Spurious elevation of automated platelet counts in secondary acute monocytic leukemia associated with tumor lysis syndrome. Arch. Pathol. Lab. Med. 1999, 123, 1111–1114. [Google Scholar] [CrossRef]
- Christopoulos, C.; Mattock, C. Platelet satellitism and alpha granule proteins. J. Clin. Pathol. 1991, 44, 788–789. [Google Scholar] [CrossRef]
- Innes, A.J.; Matthey, F. Red cell fragments can mask severe thrombocytopenia. Blood 2017, 130, 1484. [Google Scholar] [CrossRef]
- Lesesve, J.F.; Vila, L. EDTA-dependent lymphoagglutination. Lab. Hematol. 2008, 14, 35–37. [Google Scholar] [CrossRef] [PubMed]
- van der Meer, W.; MacKenzie, M.A.; Dinnissen, J.W.; de Keijzer, M.H. Pseudoplatelets: A retrospective study of their incidence and interference with platelet counting. J. Clin. Pathol. 2003, 56, 772–774. [Google Scholar] [CrossRef] [PubMed]
- Bizzaro, N.; Goldschmeding, R.; von dem Borne, A.E. Platelet satellitism is Fc gamma RIII (CD16) receptor-mediated. Am. J. Clin. Pathol. 1995, 103, 740–744. [Google Scholar] [CrossRef] [PubMed]
- McGregor, D.H.; Davis, J.W.; Liu, P.I.; Gates, E.; Poindexter, A.R. Platelet satellitism: Experimental studies. Lab. Investig. 1980, 42, 343–355. [Google Scholar]
- Tessier-Marteau, A.; Genevieve, F.; Godon, A.; Macchi, L.; Zandecki, M. Automated hematology analysers and spurious counts. Part 1. Platelets. Ann. Biol. Clin. (Paris) 2010, 68, 393–407. [Google Scholar] [CrossRef]
- Cooper, N.; Ghanima, W. Immune thrombocytopenia. N. Engl. J. Med. 2019, 381, 945–955. [Google Scholar] [CrossRef]
- Balduini, C.L.; Pecci, A.; Noris, P. Inherited thrombocytopenias: The evolving spectrum. Hamostaseologie 2012, 32, 259–270. [Google Scholar] [CrossRef]
- Noris, P.; Pecci, A. Hereditary thrombocytopenias: A growing list of disorders. Hematol. Am. Soc. Hematol. Educ. Progr. 2017, 2017, 385–399. [Google Scholar] [CrossRef]
- Noris, P.; Schlegel, N.; Klersy, C.; Heller, P.G.; Civaschi, E.; Pujol-Moix, N.; Fabris, F.; Favier, R.; Gresele, P.; Latger-Cannard, V.; et al. Analysis of 339 pregnancies in 181 women with 13 different forms of inherited thrombocytopenia. Haematologica 2014, 99, 1387–1394. [Google Scholar] [CrossRef]
- Schafer, A.I. Thrombocytosis. N. Engl. J. Med. 2004, 350, 1211–1219. [Google Scholar] [CrossRef]
- Lawrence, C.; Atac, B. Hematologic changes in massive burn injury. Crit. Care Med. 1992, 20, 1284–1288. [Google Scholar] [CrossRef] [PubMed]
- Briggs, C.; Harrison, P.; Machin, S.J. Continuing developments with the automated platelet count. Int. J. Lab. Hematol. 2007, 29, 77–91. [Google Scholar] [CrossRef] [PubMed]
- Ballard, H.S.; Sidhu, G. Cytoplasmic fragments causing spurious platelet counts in hairy cell leukemia: Ultrastructural characterization. Arch. Intern. Med. 1981, 141, 942–944. [Google Scholar] [CrossRef] [PubMed]
- Kakkar, N.; Garg, G. Cytoplasmic fragments of leukaemic cells masquerading as platelets in an automated haematology analyser. J. Clin. Pathol. 2005, 58, 224. [Google Scholar]
- Kakkar, N. Spurious rise in the automated platelet count because of bacteria. J. Clin. Pathol. 2004, 57, 1096–1097. [Google Scholar] [CrossRef]
- Serraj, K.; Mecili, M.; Azzouzi, H.; Ghiura, C.F.; Andres, E. Les thrombocytoses: Physiopathologie, diagnostic et traitement. Méd. Thér. 2012, 18, 11–20. [Google Scholar]
- Harrison, C.N.; Bareford, D.; Butt, N.; Campbell, P.; Conneally, E.; Drummond, M.; Erber, W.; Everington, T.; Green, A.R.; Hall, G.W.; et al. Guideline for investigation and management of adults and children presenting with a thrombocytosis. Br. J. Haematol. 2010, 149, 352–375. [Google Scholar] [CrossRef]
- Mathur, A.; Samaranayake, S.; Storrar, N.P.; Vickers, M.A. Investigating thrombocytosis. BMJ Clin. Res. Ed. 2019, 366, l4183. [Google Scholar] [CrossRef]
- Cornet, E.; Mullier, F.; Despas, N.; Jacqmin, H.; Geara, C.; Boubaya, M.; Chatelain, B.; Troussard, X. Evaluation and optimization of the extended information process unit (E-IPU) validation module integrating the sysmex flag systems and the recommendations of the French-speaking cellular hematology group (GFHC). Scand. J. Clin. Lab. Investig. 2016, 76, 465–471. [Google Scholar] [CrossRef]
- Arber, D.A.; Orazi, A.; Hasserjian, R.; Thiele, J.; Borowitz, M.J.; Le Beau, M.M.; Bloomfield, C.D.; Cazzola, M.; Vardiman, J.W. The 2016 revision to the World Health Organization classification of myeloid neoplasms and acute leukemia. Blood 2016, 127, 2391–2405. [Google Scholar] [CrossRef]
- Carobbio, A.; Ferrari, A.; Masciulli, A.; Ghirardi, A.; Barosi, G.; Barbui, T. Leukocytosis and thrombosis in essential thrombocythemia and polycythemia vera: A systematic review and meta-analysis. Blood Adv. 2019, 3, 1729–1737. [Google Scholar] [CrossRef] [PubMed]
- Tefferi, A.; Barbui, T. Polycythemia vera and essential thrombocythemia: 2015 update on diagnosis, risk-stratification and management. Am. J. Hematol. 2015, 90, 162–173. [Google Scholar] [CrossRef] [PubMed]
- Fujiwara, T.; Harigae, H.; Kameoka, J.; Yokoyama, H.; Takahashi, S.; Tomiya, Y.; Yamada, M.; Ishizawa, K.; Imaizumi, M.; Sasaki, T. A case of familial thrombocytosis: Possible role of altered thrombopoietin production. Am. J. Hematol. 2004, 76, 395–397. [Google Scholar] [CrossRef] [PubMed]
- Rumi, E.; Cazzola, M. Diagnosis, risk stratification, and response evaluation in classical myeloproliferative neoplasms. Blood 2017, 129, 680–692. [Google Scholar] [CrossRef]
- Barbui, T.; Tefferi, A.; Vannucchi, A.M.; Passamonti, F.; Silver, R.T.; Hoffman, R.; Verstovsek, S.; Mesa, R.; Kiladjian, J.-J.; Hehlmann, R.; et al. Philadelphia chromosome-negative classical myeloproliferative neoplasms: Revised management recommendations from European LeukemiaNet. Leukemia 2018, 32, 1057–1069. [Google Scholar] [CrossRef]
- Rumi, E.; Cazzola, M. How I treat essential thrombocythemia. Blood 2016, 128, 2403–2414. [Google Scholar] [CrossRef]

© 2020 by the authors. Licensee MDPI, Basel, Switzerland. This article is an open access article distributed under the terms and conditions of the Creative Commons Attribution (CC BY) license (http://creativecommons.org/licenses/by/4.0/).
Share and Cite
Baccini, V.; Geneviève, F.; Jacqmin, H.; Chatelain, B.; Girard, S.; Wuilleme, S.; Vedrenne, A.; Guiheneuf, E.; Toussaint-Hacquard, M.; Everaere, F.; et al. Platelet Counting: Ugly Traps and Good Advice. Proposals from the French-Speaking Cellular Hematology Group (GFHC). J. Clin. Med. 2020, 9, 808. https://doi.org/10.3390/jcm9030808
Baccini V, Geneviève F, Jacqmin H, Chatelain B, Girard S, Wuilleme S, Vedrenne A, Guiheneuf E, Toussaint-Hacquard M, Everaere F, et al. Platelet Counting: Ugly Traps and Good Advice. Proposals from the French-Speaking Cellular Hematology Group (GFHC). Journal of Clinical Medicine. 2020; 9(3):808. https://doi.org/10.3390/jcm9030808
Chicago/Turabian StyleBaccini, Véronique, Franck Geneviève, Hugues Jacqmin, Bernard Chatelain, Sandrine Girard, Soraya Wuilleme, Aurélie Vedrenne, Eric Guiheneuf, Marie Toussaint-Hacquard, Fanny Everaere, and et al. 2020. "Platelet Counting: Ugly Traps and Good Advice. Proposals from the French-Speaking Cellular Hematology Group (GFHC)" Journal of Clinical Medicine 9, no. 3: 808. https://doi.org/10.3390/jcm9030808
APA StyleBaccini, V., Geneviève, F., Jacqmin, H., Chatelain, B., Girard, S., Wuilleme, S., Vedrenne, A., Guiheneuf, E., Toussaint-Hacquard, M., Everaere, F., Soulard, M., Lesesve, J.-F., & Bardet, V. (2020). Platelet Counting: Ugly Traps and Good Advice. Proposals from the French-Speaking Cellular Hematology Group (GFHC). Journal of Clinical Medicine, 9(3), 808. https://doi.org/10.3390/jcm9030808

